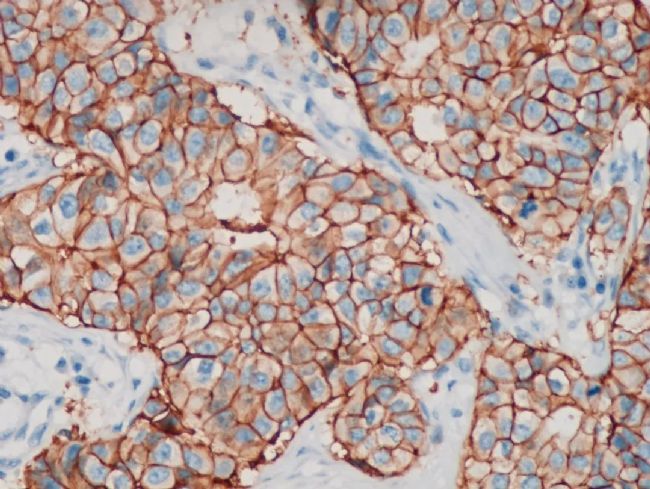
3.jpg

1. 癌癥與癌細(xì)胞
癌癥通常是由于細(xì)胞基因發(fā)生錯(cuò)誤或不正確的表達(dá),使細(xì)胞分化和增殖異常,生長(zhǎng)失去控制,并可侵襲身體的臨近部位和擴(kuò)散到其它器官。
癌細(xì)胞與正常細(xì)胞相比,有以下幾點(diǎn)不同:
1、無限增殖,失去生長(zhǎng)控制的調(diào)控,相比于正常細(xì)胞最大分裂次數(shù)的限制,癌細(xì)胞可無限增殖
2、組織浸潤(rùn)與轉(zhuǎn)移,主要是具備了上皮間質(zhì)轉(zhuǎn)化的能力,所以能夠通過循環(huán)系統(tǒng)到達(dá)遠(yuǎn)處的實(shí)質(zhì)組織,除此之外也可以直接向周圍的實(shí)質(zhì)組織浸潤(rùn)
3、形態(tài)大小變化,正常細(xì)胞大小相對(duì)一致,而癌細(xì)胞內(nèi)的細(xì)胞核體積多樣,會(huì)出現(xiàn)巨核,雙核,多核或異形核形態(tài),細(xì)胞漿的質(zhì)和量也跟正常細(xì)胞有一定差別
4、免疫逃避,癌細(xì)胞通過多種機(jī)制逃避免疫系統(tǒng)的監(jiān)視和清除,最主要的是癌細(xì)胞表面具有與免疫細(xì)胞結(jié)合的表達(dá)免疫檢查點(diǎn)分子,從而避免免疫細(xì)胞發(fā)揮作用
5、誘導(dǎo)血管生成,細(xì)胞長(zhǎng)時(shí)間存活需要持續(xù)提供營(yíng)養(yǎng)和氧氣,這些也是腫瘤細(xì)胞需要的物質(zhì)。癌細(xì)胞可以誘導(dǎo)血管生成獲得必要營(yíng)養(yǎng)。在癌癥的發(fā)展期間,血管還會(huì)隨著腫瘤的生長(zhǎng)不斷生存,保持著比較完善的血管系統(tǒng),因此在發(fā)現(xiàn)癌癥的時(shí)候,就只有進(jìn)行切除,才能夠?qū)⒛[瘤徹底解決。
2. 顯微成像技術(shù)在癌癥研究中的應(yīng)用
依據(jù)癌細(xì)胞在分子表達(dá)層面和細(xì)胞組織層面的變化,運(yùn)用各類顯微成像技術(shù)對(duì)癌細(xì)胞進(jìn)行篩選與識(shí)別,以下是在癌癥研究中常見的幾類顯微成像技術(shù)應(yīng)用:
(1)病理切片通過手術(shù)切除或穿刺活檢得到腫瘤組織來進(jìn)行分子分型是臨床上判斷癌癥的金標(biāo)準(zhǔn)。病理切片如何確認(rèn)是否有癌細(xì)胞的關(guān)鍵要在于顯微鏡下的觀察,通常是在顯微鏡下對(duì)病理切片進(jìn)行染色以后觀察其中的細(xì)胞的形態(tài)是否滿足癌細(xì)胞的特征。
常用的染色方法是蘇木素-伊紅(Hematoxylin-Eosin)染色法,簡(jiǎn)稱H.E染色法。這種方法對(duì)任何固定液固定的組織和應(yīng)用各種包埋法的切片均可使用。蘇木素是一種堿性染料,可使組織中的嗜堿性物質(zhì)染成藍(lán)色,如細(xì)胞核中的染色質(zhì)等;伊紅是一種酸性染料,可使組織中的嗜酸性物質(zhì)染成紅色,如多數(shù)細(xì)胞的胞質(zhì)、核仁等在H.E染色的切片中均呈紅色。

明美生物顯微鏡搭配msx2拍攝HE染色的乳腺癌病理切片,紅色為胞質(zhì),藍(lán)色為染色體
(2)免疫組化(IHC)免疫組化,通俗的含義就是把癌組織中的癌細(xì)胞放大到分子級(jí)別,通過顯微鏡看看在這個(gè)水平上有哪些跟別的細(xì)胞不一樣的特征,因?yàn)榈鞍踪|(zhì)在體內(nèi)出現(xiàn)的位置不一樣,有的蛋白遍布全身,有的蛋白只出現(xiàn)在某些特定的器官與組織中,通過直接直觀地觀察組織和細(xì)胞里是否存在一些蛋白質(zhì)的方法,來確定腫瘤的分子分型,判斷腫瘤的原發(fā)位置,腫瘤惡性程度及預(yù)后效果。

ML51+MSX2拍攝的免疫組化病理組織
IHC-HER2檢測(cè),癌細(xì)胞形態(tài)變化,伴隨血管生成
(3)原位熒光雜交(FISH)熒光原位雜交技術(shù)是一種使用熒光素標(biāo)記探針,以檢測(cè)探針和分裂中期的染色體或分裂間期的染色質(zhì)的雜交。其基本原理是:以核酸堿基互補(bǔ)配對(duì)原則為基礎(chǔ)所發(fā)展起來的檢測(cè)技術(shù),主要利用DNA序列的互補(bǔ)性,通過熒光標(biāo)記的DNA探針與預(yù)處理的待測(cè)樣本的DNA進(jìn)行原位雜交,在熒光顯微鏡下, 對(duì)熒光信號(hào)進(jìn)行辨別和計(jì)數(shù),即可對(duì)細(xì)胞、組織樣本中的染色體或基因異常進(jìn)行檢測(cè)和診斷。
不同種類癌細(xì)胞具有特異性的基因片段,使用FISH技術(shù)進(jìn)行特異性標(biāo)記,通過特異性熒光信號(hào)的表達(dá)特征,來判斷是否有癌細(xì)胞或癌細(xì)胞種類。臨床應(yīng)用中,在乳腺癌、宮頸癌、膀胱癌、血液腫瘤等診斷和指導(dǎo)用藥等方面,F(xiàn)ISH有極強(qiáng)的優(yōu)勢(shì)。

MF43-N+MC50-S搭配四波段光源拍攝的FISH圖像
(4)循環(huán)腫瘤檢測(cè)(CTC)癌細(xì)胞具有組織浸潤(rùn)和轉(zhuǎn)移的特征,可以脫離原發(fā)病灶進(jìn)入循環(huán)系統(tǒng)。循環(huán)腫瘤細(xì)胞就是指從實(shí)體瘤中脫離出來并進(jìn)入外周血液循環(huán)的腫瘤細(xì)胞。通過對(duì)血液中CTC的數(shù)量以及蛋白表達(dá)、基因序列的檢測(cè)等,可以獲得腫瘤的相關(guān)病變的信息,可以彌補(bǔ)腫瘤組織難以獲得的局限性,而且CTC可以重復(fù)進(jìn)行取樣,具有實(shí)時(shí)監(jiān)測(cè)的功能。

MF43-N拍攝的CTC檢測(cè)
(5)腫瘤細(xì)胞培養(yǎng)研究腫瘤細(xì)胞培養(yǎng)是研究癌變機(jī)理、腫瘤細(xì)胞及其特征分子生物學(xué)特征、藥物敏感性的重要手段。癌細(xì)胞是目前所建立的細(xì)胞系中占比最多的,該應(yīng)用對(duì)腫瘤研究具有很多優(yōu)點(diǎn):①便于從細(xì)胞水平上對(duì)腫瘤細(xì)胞結(jié)構(gòu)功能進(jìn)行研究,同時(shí)也可從基因及分子水平上對(duì)癌變機(jī)理進(jìn)行探究;②可長(zhǎng)期傳代,便于對(duì)腫瘤細(xì)胞生物學(xué)特征和遺傳行為進(jìn)行觀察研究;③可用于快速篩選藥物及耐藥機(jī)理研究。

腫瘤細(xì)胞培養(yǎng)-劃痕實(shí)驗(yàn)
3. 顯微成像在癌癥研究應(yīng)用中的難點(diǎn)
(1)多色熒光顯微成像中各熒光團(tuán)信號(hào)的獲得
癌細(xì)胞通常具有一個(gè)或多個(gè)特異性的標(biāo)記物,對(duì)應(yīng)的需要使用多種熒光染料或熒光探針,如何在一張圖像中獲得多通道的熒光信號(hào)具有一定的挑戰(zhàn)性。挑戰(zhàn)主要來自以下幾個(gè)方面:
①激發(fā)光源,多通道熒光成像要求激發(fā)光源有比較寬的光譜,在熒光染料或熒光探針的激發(fā)光譜有比較好的峰值特征;②濾光片,針對(duì)不同熒光染料選擇合適的濾光片,保證熒光信號(hào)的通過,避免其他雜光的干擾;③成像質(zhì)量,熒光信號(hào)通常比較微弱,選用高靈敏度的相機(jī),有利于捕獲微弱的熒光信號(hào);④熒光圖像處理,針對(duì)多通道熒光圖像疊加的處理方式,需要保證疊加圖像的穩(wěn)定性和清晰度。
(2)病理切片的判讀與掃描
臨床上,通過病理切片對(duì)癌細(xì)胞進(jìn)行分子分型是癌癥診斷的金標(biāo)準(zhǔn)。典型的病理觀察是通過移動(dòng)載物臺(tái)在高倍物鏡下找到局部病變組織并進(jìn)行判斷和分型,這一方法有幾點(diǎn)限制:
①高倍鏡成像區(qū)域較小,對(duì)整個(gè)切片組織中的異常細(xì)胞進(jìn)行定位需要多次移動(dòng)載物臺(tái),耗時(shí)耗力,對(duì)操作人員要求較高;②無法在一張圖上對(duì)整個(gè)切片組織進(jìn)行成像,無法滿足對(duì)判斷病理組織整體形態(tài)特征的需求。對(duì)此的解決方案一般是采用切片掃描系統(tǒng),通過電動(dòng)化的掃描平臺(tái)和拼接分析軟件,獲得高分辨率全局圖,方便對(duì)切片組織整體形態(tài)進(jìn)行病理分析,同時(shí)可以方便定位局部病理組織并進(jìn)行放大觀察。
4. 明美解決方案


(1)全能型:切片掃描系統(tǒng)+常規(guī)明場(chǎng)熒光成像二合一推薦:明美數(shù)字切片掃描系統(tǒng)+MF43-N+MSX2/MS60
同時(shí)兼顧少量切片掃描需求與常規(guī)明場(chǎng)熒光觀察功能
明美切片掃描系統(tǒng)可單獨(dú)搭配部分四大各品牌
可應(yīng)用于常規(guī)病理切片掃描觀測(cè)、CTC、FISH、IHC檢測(cè)等


(2)FISH、CTC、IHC檢測(cè)推薦:MF43-N/MF53-N+MC50-S/MS23+FISH軟件
配備熒光模塊,依據(jù)研究觀測(cè)需要,可搭配B\G\U\Y\R等熒光通道
高靈敏度相機(jī),微弱熒光信號(hào)也能清晰成像
FISH軟件,智能優(yōu)化熒光圖像,一鍵合成多色熒光圖像


(3)常規(guī)明場(chǎng)切片觀察推薦:ML31/ML41/ML51+MS60/MSX2
高品質(zhì)物鏡,高分辨率成像,細(xì)節(jié)把握更清晰
高穩(wěn)定性載物臺(tái),長(zhǎng)時(shí)間使用更輕松
高分辨率相機(jī),圖像真實(shí)色彩高還原


(4)癌細(xì)胞培養(yǎng)研究觀測(cè)推薦:活細(xì)胞成像儀+平板/手機(jī)
小巧輕便,放置在超凈工作臺(tái)上不占空間
無線連接手機(jī)或平板電腦,避免接觸造成污染
可集約化配備明場(chǎng)、相差和單色或多色熒光功能,應(yīng)對(duì)不同細(xì)胞觀測(cè)要求


(5)四大各品牌熒光顯微鏡升級(jí)推薦:正置6孔熒光轉(zhuǎn)盤/原配熒光臂 + MG-100/MG-120 + MS23/MC50-S + MFISH軟件
明美提供多種不同規(guī)格濾光片組,適配四大各品牌主流熒光模塊
MG-100/MG-120新型LED熒光光源有穩(wěn)定的激發(fā)效果,即開即用壽命長(zhǎng)
高靈敏度相機(jī)MS23/MC50-S,搭配MFISH軟件滿足高質(zhì)量FISH成像需要
升級(jí)成本性價(jià)比高,熒光效果出色
明美是一家專注顯微成像產(chǎn)品研發(fā)與銷售的高新技術(shù)企業(yè),是中國(guó)儀器儀表行業(yè)協(xié)會(huì)光學(xué)分會(huì)理事單位,醫(yī)療器械顯微鏡生產(chǎn)及經(jīng)營(yíng)廠家。
公司一直堅(jiān)持誠(chéng)信經(jīng)營(yíng),用心服務(wù),提供顯微成像解決方案。為教育、科研、醫(yī)藥、工業(yè)檢測(cè)等廣大客戶提供高效、穩(wěn)定的產(chǎn)品與服務(wù)。
始終以客戶需求為中心,以品質(zhì)為根本,以創(chuàng)新為方向,推動(dòng)顯微行業(yè)的數(shù)字化、電動(dòng)化、智能化,為顯微領(lǐng)域的國(guó)產(chǎn)化進(jìn)程貢獻(xiàn)力量。
您若對(duì)顯微成像產(chǎn)品有興趣或存在疑惑,明美光電歡迎您咨詢,咨詢電話:400-880-1910,期待與您相約!